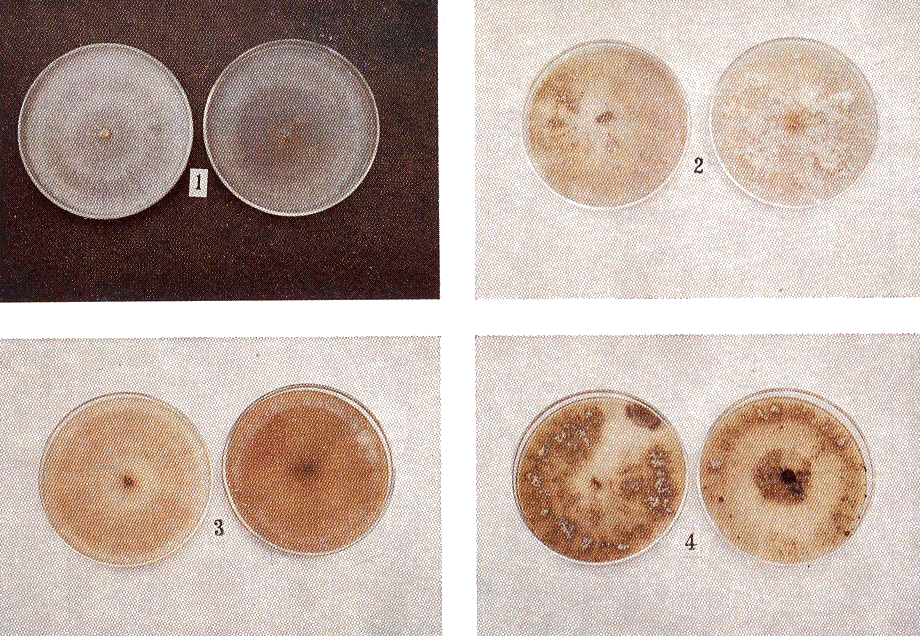
Fig. 1. Los cuatro grupos sub-espec�ficos de Rhizoctonia solani que demostraron mayor frecuencia de aislamiento.

Agronomía Tropical 23(1): 47-63. 1973
VARIABILIDAD EN LA VIRULENCIA DE GRUPOS SUBESPECIFICOS DE
Rhizoctonia salani PATOGENICOS EN LEGUMINOSAS(a)
C. Díaz Polanco* y G. Salas De Díaz*
(a)Se agradece la colaboración de los peritos agropecuarios.
Jorge
Cortez, Ramona Reina, Gloria Landaeta y Pablo Maurazutt,
durante pasantías
del PRIDA.
(b)Centro de Investigaciones Agronómicas.
Maracay, Venezuela.
INTRODUCCION
La identificación de Rhizoctonia solani (Thanatephorus cucumeris) y su separación de otras especies con morfología similar (con estados perfectos localizados en el géreno Ceratobasidium), ha sido extensa y apropiadamente discutida por PARMETER et al. (9).
La clasificación de la especie Rhizoctonia solani (estado imperfecto) se basa en características bien definidas, las cuales han sido concebidas así (9):
1) Células jóvenes (en regiones apicales de hifas) con 6 a 10 núcleos.
2) Aparato septal complejo.
3) Ramificación característica de hifas (aproximándose a ángulos de 90°).
4) Pigmentación del micelio siempre alguna forma de marrón (nunca otro color).
5) Células monilioides en cultivos jóvenes, formando estromas escleróticos, o en relación a hifas especializadas de penetración del hospedero.
6) Esclerocios sin diferenciación entre epidermis y médula, de forma variable (desde globosos hasta estro mas delgados de bordes irregulares).
7) Patogenicidad típica en hipocotilo de ciertos hospedantes (ejemplo: leguminosas).
8) Estado sexual dentro de la especie Thanatephorus cucumeris.
La especialización patológica de Rhizoctonia solani quedó demostrada cuando se señaló que dos tipos morfológicamente similares, pueden tener diferencias en patogenicidad sobre un mismo hospedante. Además, tipos subespecíficos con igual morfología, aun teniendo el mismo grado de virulencia hacia un hospedante, pueden no tenerlo igual con respecto a otro cultivo hospedero (5).
La existencia de razas de R. solani aisladas de Phaseolus vulgaris ha sido previamente postulada en la bibliografía (4), proponiéndose una correlación entre morfología, fisiología y patogenicidad que define diferentes razas patogénicas sobre P. vulgaris.
Por otra parte, en base a estas mismas ideas se ha determinado la existencia de 4 grandes grupos sub específicos, los cuales demuestran aislamiento genético debido a la falta de anastomosis compatible entre ellos. Este hecho explicaría un proceso de desarrollo divergente dentro de la especie (11, 13, 14). Estos 4 grupos incompatibles han sido designados bajo las siglas de AG-1 al AG-4, existiendo un gran número de variaciones morfológicas y fisiológicas dentro de cada grupo (8, 9, 10, 11).
Algunos de los criterios más importantes utilizados para diferenciar grupos ("razas") subespecíficos son: lista de hospederos, virulencia hacia un hospedero determinado, tipo de enfermedad que causa (tejido del hospedero invadido por el hongo), temperaturas óptimas de crecimiento y de patogenicidad, habilidad de supervivencia en partes profundas del suelo (tolerancia de altas concentraciones de CO2), habilidad de sobrevivir en ciertos suelos, producción de esclerocios y rata de crecimiento (2, 6, 7).
La variabilidad dentro de la especie reside en la condición heterocariótica de la multinucleación celular. Esta heterocariosis puede provenir de mutaciones, recombinación sexual, o por anastomosis entre hifas de biotipos compatibles (3). Las extensas posibilidades de variación dentro de los grupos sub específicos ya mencionados, son quizás responsables por la lista de sinónimos con los cuales se han descrito aislamientos que caben dentro de la especie R. solani (9, 12). Esta lista se ofrece a continuación para dejar la materia debidamente aclarada en el país.
Estado asexual (imperfecto):
Rhizoctonia solani KÜHN.
Sinónimos: R. microsclerotia, R. gossypii, R. dichotoma, R. praticola.
Sinónimos
probables: R. napaeae, R. rapae, R. betae, R. potomacensis, R.
macrosclerotia, R. dimorpha, R. melogena, R. lupini, R. aderholdii.
Estado
sexual: Thanatephorus cucumeris (FRANK) DONK.
Sinónimos: T. praticola,
Hypochnus cucumeris, H. filamentosus, H. solani, H. sasakii, Corticium
vagum, C. solani, C. sasakii, C. aerolatum, C. microsc1erotia, Botryobasidium salani, PeIlicularia filamentosa,
Ceratobasidium filamentosum, C salani.
La mayoría de los sinónimos mencionados han caído en desuso y para mayor claridad deberían ser sustituidos totalmente por los dos binomios aceptables: Thanatephorus cucumeris (Rhizoctonia salani).
Anteriormente habíamos analizado la virulencia de algunas cepas de R. salani obtenidas de semilla de caraota (1). Ahora pretendemos estudiar la patogenicidad de biotipos aislados de diferentes tejidos (semilla, hipocotilo, follaje, etc.) de varios hospedantes. Interesa aclarar si los aislamientos obtenidos de diferentes hospedantes y zonas geográficas, presentan variabilidad morfológica y en su patogenicidad hacia Phaseolus vulgaris.
La información que se presenta aquí es sólo un aporte inicial.
Es interesante hacer notar por ejemplo, que en Venezuela no se ha reportado aún la existencia del estado sexual.
Mucho queda por hacer y esperamos que otros contribuyan a la búsqueda de las respuestas necesarias para aclarar la situación de este importante patógeno en Venezuela.
MATERIALES Y METODOS
a) Descripción de los biotipos
La colección de aislamientos se inició en el año de 1964. Los aislamientos se conservaron en agar papa y se describió su morfología en planitlas convenientemente diseñadas. Algunos aislamientos se conservaron, pero aquellos que se hacían repetitivos eran eliminados una vez que quedaba asentada su descripción morfológica y se tomaba nota de su patogenicidad sobre caraota varo Cubagua (Phaseolus vulgaris L.).
Todos los biotipos fueron descritos en base a cultivos monocelulares. En primer lugar, se obtuvo la identificación del organismo como perteneciente a la especie R. salani, luego se describían las características morfológicas. (Cuadros 1 y 2, fig. 1).
b) Compatibilidad de los aislamientos
Observaciones con respecto a compatibilidad se tomaron oponiendo diferentes aislamientos en platos de cultivo (se utilizaron medios de agar papa o de agua, según fuese conveniente). En aquellas áreas' en que cultivos opuestos en un mismo plato entraban en contacto directo, se tomaban secciones para observación al microscopio separando segmentos de estas hifas, las cuales se transferían individualmente a platos de cultivo cuando se consideraba necesario determinar su viabilidad.
CUADRO 1. Características de los grupos subespecíficos de R. Solani(1)
CUADRO 2. Abundacia y distribución geográficas de grupos subespecíficos de R. Solani(1)
|
|
Fig. 1. Los cuatro grupos sub-específicos de Rhizoctonia solani que demostraron mayor frecuencia de aislamiento. |
c) Prueba de patogenicidad
Cada aislamiento fué inoculado sobre semillas y plántulas de la variedad Cubagua.
El inóculo se preparó haciendo una suspensión mediante maceración del tejido joven del hongo (cultivo de 10 a 25 días) en agua destilada y esterilizada. Se usaron 20 gr. del hongo por cada 200 cc. de agua.
La inoculación se practicó sumergiendo en el inóculo a la semilla del hospedero. Luego la semilla se sembró en tierra previamente tratada con Bromuro de Metilo, incorporándose a la tierra el inóculo sobrante, 10 cual daba una concentración final de 6000 propágulos del hongo (trozos multicelulares de hifas) por gramo de tierra (± 10%).
Los resultados de estas pruebas aparecen en el Cuadro 3 y Fig. 2. También se practicaron inoculaciones en condiciones de campo. Se sembraron 2 hilos de 10 metros separados a 60 cm., con espacios de 10 cm. entre plantas. A los 5 días se seleccionaron 100 plantas al azar y se les inoculó aplicando en el hipocotilo una suspensión acuosa del patógeno (10 cc/planta) preparada en la forma ya indicada. Al final del ciclo, se tomaron datos de producción por planta. Estos resultados aparecen en el Cuadro 4.
d) Observaciones de campo
En cada observación, se determinó la densidad de población de cada campo de caraota. Luego se tomó un hilo al azar y se extrajeron de él las plantas que demostraban desarrollo general inferior al resto de la población.
Esta muestra se llevó al laboratorio en donde se procesó identificando los patógenos o de ser posible, otras causas de su desarrollo inferior a lo normal.
Este tipo de muestreo se realizó cada Sólo días durante los primeros 50 del ciclo. De esta manera se hicieron muestreos periódicos en 10 campos de caraotas.
Los resultados se expresan en el Cuadro 3.
RESULTADOS Y DISCUSION
La frecuencia aislamiento, zonas geográficas de procedencia y las de otras características de los 6 grupos del hongo se expresan en los cuadros 1 y 2.
El hábito de crecimiento, la producción de esclerocios, la pigmentación de los aislamientos, así como la presencia de micelio aéreo y la reacción de patogenicidad (sobre caraota 'Cubagua'), fueron caracteres que al demostrar alto grado de estabilidad en cultivos mono celulares, permitieron la consideración de estas formas de R. solani como grupos subespecíficos. La frecuencia con que se practicaron los aislamientos, nos permitió determinar que ocurren libremente en la naturaleza, algunos con mayor prevalencia que otros. Se hace evidente por ésto que en zonas ecológicas diferentes, algunos grupos son más abundantes que otros, y en muchos casos no comparten la misma zona ecológica. Por último, la reacción de compatibilidad en anastomosis de hifas entre aislamientos procedentes de diferentes grupos, indica la relación estrecha y la condición de intercambiabilidad genética que los caracteriza.
Esa situación debería de permitir un alto grado de variabilidad por recombinación genética entre diferentes grupos. Sin embargo ,ya que los grupos no comparten la misma zona geográfica, es posible que en condiciones naturales, no se exprese todo el potencial de re combinación genética por anastomosis compatible y formación de heterocariontes. Esta consideración adquiere mayor validez al observar la homogeneidad mOffológica que existe dentro de cada una de las 6 agrupaciones subespecíficas. Se ha demostrado anteriormente que la especialización en lo relativo al habitat, es debida a la imposibilidad de algunos tipos de R. solani para sobrevivir en ciertos suelos (7). En nuestro caso, aunque no se investigó lo relativo a esta situación, la casi exclusiva concentración de ciertos grupos del hongo en zonas específicas y claramente definidas, pudiera ser el reflejo de una condición similar.
|
CUADRO 3. Patogenicidad de diferentes grupos sub-específico de R. solani en caraota (var. "Cubagua"). |
||||||||||
|
|
||||||||||
| Grupo Nº |
Aisl. Nº |
Origen (1) % | PLANTAS CON LESIONES EN: | FOLLAJE | Grado de Infección (2) | |||||
| Raíces | Tallos | Cotiledones | Primario | Apice | ||||||
|
|
||||||||||
| 1 | R-2 | Pa. | 2 | 90 | 60 | 60 | 50 | 2,0 | ||
| 1 | 14 | Gm. | 0 | 70 | 50 | 65 | 75 | 2,5 | ||
| 1 | 26 | Pv. | 0 | 40 | 50 | 25 | 40 | 1,5 | ||
| 2 | 5 | Pv. | 15 | 20 | 10 | 10 | 10 | 1,0 | ||
| 2 | 21 | T | 25 | 30 | 40 | 0 | 0 | 1,5 | ||
| 2 | 87 | Vs. | 10 | 45 | 50 | 0 | 15 | 1,0 | ||
| 3 | 13 | Pv. | 0 | 80 | 70 | 40 | 40 | 2,0 | ||
| 3 | 23 | Pv. | 0 | 95 | 80 | 90 | 90 | 2,8 | ||
| 3 | 75 | Gm. | 0 | 70 | 55 | 75 | 75 | 2,5 | ||
| 4 | 17 | A | 0 | 65 | 70 | 60 | 0 | 2,6 | ||
| 4 | 93 | Pv. | 10 | 60 | 70 | 60 | 0 | 2,0 | ||
| 4 | 104 | St. | 10 | 50 | 50 | 40 | 25 | 1,5 | ||
| 5 | 8 | Vs. | 15 | 40 | 20 | 0 | 15 | 1,0 | ||
| 5 | 112 | Vs. | 0 | 50 | 20 | 0 | 0 | 1,2 | ||
| 5 | 131 | Pv. | 0 | 60 | 20 | 10 | 25 | 1,0 | ||
| 6 | 18 | St. | 20 | 35 | 50 | 0 | 40 | 0,5 | ||
| 6 | 120 | St. | 10 | 50 | 30 | 0 | 60 | 1,0 | ||
| 6 | 125 | St. | 10 | 60 | 25 | 0 | 60 | 1,0 | ||
|
|
||||||||||
|
(1) Hospederos de origen del hogon: |
(2) Grado de infección en tallos (hipocotilo) |
|||||||||
| Pa = Phaseolus
aureus Gm = Glycine max Pv = P. vulgaris T = P. lunatus Vs = Vignia sinensis St = Solanun tuberosum A = Arveja |
0 = Sin nfección |
|||||||||
La patogenicidad de los 6 grupos sobre el cultivar de caraota 'Cubagua' se expresa en el Cuadro 3. Vale la pena mencionar que aparecen en el cuadro sólo aislamientos típicos de cada grupo y no los 149 biotipos obtenidos, para no recargar el trabajo con datos redundantes, ya que los otros biotipos dentro de cada grupo, demostraron comportamiento similar a los anotados. Puede notarse que los aislamientos demuestran diferencias en su habilidad para atacar diferentes partes de la planta hospedera. Este fenómeno demostró no estar relacionado al origen del aislamiento. Por ejemplo, el aislamiento 87 fué obtenido de follaje y sin embargo demuestra mayor actividad patogénica sobre cotiledones y tallo. Igualmente el aislamiento 104 fue obtenido de raíces y tubérculos de papa, demostrando mayor daño sobre tallos, cotiledones y follaje de 'Cubagua'. Hay numerosos otros ejemplos de este tipo que indican sin lugar a dudas, que no hay especialización demostrable en el material recolectado, en cuanto a actividad patogénica aérea o subterránea.
Los biotipos correspondientes a los grupos 1, 3 y 4 demostraron mayor patogenicidad sobre caraota, aun en aquellos casos de aislamientos provenientes de especies diferentes de Phaseolus vulgaris. Además debe añadirse que en los aislamientos comprendidos dentro de los grupos 2, 5 y 6 se observó menor acción patogénica, aun cuando algunos provenían de caraota.
|
CUADRO 4. Diferencias en rendimientos entre plantas de caraotas sanas y afectadas por R. solani(1). |
|||
|
|
|||
| PLANTAS | |||
| (TESTIGOS) SANAS |
(INOCULADAS) INFECTADAS |
||
|
|
|||
| Nº Vainas/planta | 25-33 | 9-12 | |
| . | Semillas/vaina | 5-6 | 4 |
| . | Semillas/planta | 125 | 38 |
| . | Peso (gr.) semillas/planta | 10,5-12 | 5,5-5,8 |
| Nº inicial de plantas | 100 | 100 | |
| Nº final de plantas | 84 | 32 | |
| Aislamienros de R. solani | 0 | 30 | |
|
|
|||
|
(1) Las plantas (Var. "cubagua") se mantuvieron en hilos
paralelos bajo condiciones de campo (Inoculados y Testigos). |
|||
Es evidente que, para el caso de los aislamientos mencionados en este trabajo, el hospedante de origen no demostró ser factor determinante de la patogenicidad del biotipo sobre caraota. Influye más sobre la virulencia del organismo, la agrupación morfológica subespecífica a la cual pertenece.
Por otra parte, el Cuadro 4 refleja lo que sucede en plantas que al sufrir la infección del hongo tardíamente, logran llegar a producir. El efecto más notable del hongo es sin duda su participación en la constante disminución de la densidad de población en campos comerciales (Fig. 2 der.), pero aquellas plantas que son afectadas y logran sobrevivir, también acusan una notable disminución en su capacidad de producir granos.
 |
|
Fig. 2. Rhizoctonia solani en caraota: |
Todos estos efectos, sumados a la gran variabilidad y adaptabilidad del hongo, hacen de R. solani uno de los patógenos de mayor importancia en Venezuela. En lo relativo a leguminosas, no dudamos en calificarlo como el factor patológico de mayor importancia y peligro para la producción comercial de estas plantas.
RESUMEN
Ciento cuarenta y nueve aislamientos o biotipos de patógenos comprobados como pertenecientes a la especie R. solani, se separaron en seis grupos subespecíficos en base a características morfológicas que demostraron alta estabilidad en cultivos mono celulares.
Los aislamientos demostraron variabilidad en cuanto a su patogenicidad sobre diferentes tejidos de caraota 'Cubagua' (Phaseolus vulgaris L.). Esta variabilidad no está relacionada ni con el tejido, ni con la especie del hospedero original. Influye más sobre la virulencia del organismo, la agrupación subespecífica a la cual pertenece.
Se comprobó que R. solani es una de las causas más importantes en la disminución de la densidad de población en siembras de caraota y que también disminuye notablemente la capacidad de fructificación de plantas, que aún estando infectadas, logran sobrevivir y llegar a producir.
SUMMARY
One hundred and fourty nine pathogenic isolates of Rhizoctonia solani were separated into 6 sub-specific groups on the basis of morphological and pathological characteres which showed stability on monocelular colonies.
The isolates possess pathogenical variability on different bean (var. 'Cubagua') tissues.
This pathological variability seems to be related to the sub-specific group to which they be long, rather than to the type of tissue or the host plant from where first isolated. There is no difference in relation to aerial or subterranean specialization in pathogenicity. R. solani was found to be one of the main causes diminishing population density in bean fields and it also affects the production capacity of infected plants which manage to survive.
BIBLIOGRAFIA
1. DÍAZ POLANCO, C. Virulencia de cepas de Rhizoctonia solani obtenidas de semilla de caraota (Phaseolus vulgaris). Agronomía Tropical 18: 475-479. 1968.
2. DARBIN, R. D. Factors affecting the vertical distribution of R. solani with reference to CO2 concentration. Am. J. Bot. 45: 22-25. 1959.
3. FLENTJE, N. T., H. M. STRETTON y A. R. MCKENZIE. Mechanisms of variation in Rhizoctonia solani. En: Rhizoctonia solani, Biology and Pathology. Berkeley Univ. of California Press, 1970. 235 p.
4. GÁLVEZ, GUILLERMO y CARDONA, A. C. Razas de Rhizoctonia solani en frijol. Agricultura Tropical (Colombia) 16: 456-460. 1960.
5. HOUSTON, BYRON R. Culture types and pathogenicity of isolotes of Corticium solani Phytopath. 35: 371-393. 1945.
6. KENDRICK, J. B. The influence of temperature upon the incidence of Rhizoctonia root of lima beans. Phytopaht. 41: 20. 1959.
7. OLSEN, C. M., N. FLENTJE and K. F. BAKER. Comparative survival of monobasidial cultures of Thanatephorus cucumeris in soil. Phytopaht. 57: 598-601. 1967.
8. PARMETER J. R., H. S. WHITNEY and W. D. PLATT. Affinities of some Rhizoctonia species that resemble mycelium of Thanatephorus cucumeris Phytouaht 57: 218-223. 1967.
9. PARMETER, J. R. and H. S. WHITNEY. Taxonomy and nomenclature of imperfect stage: En: Rhizoctonia solani: Biology and Pathology. Berkeley, Univ. of California Press, 1970. 255 p.
10. RICHTER, H. und R. SCHNEIDER. Untersuchungen zur morphologischen und biologischen differenzierung von Rhizoctonia solani. Phytopath Z. 20: 167-226. 1953.
11. SHERWOOD, R. T. Morphology and physiology in four anastomosis groups of Thanatephorus curcumeris Phytopath. 59: 1924-1929. 1969.
12. TALBOT, P. H. Taxonomy and nomenclature of the perfect stage. En Rhizoctonia solani. Biology and Pathology. Berkeley, Univ. of California P.ress. 1970. 255 p.
13. UI, Y. M. and Y. HARADA. Alternation of Rhizoctonia solani in a particular flax field. Ann. Phytopath. Soc. Japan 28: 270-279. 1963.
14. WEBER, G. F. An aerial Rhizoctonia on bean (Abstr.) Phytopath. 25: 38. 1935.